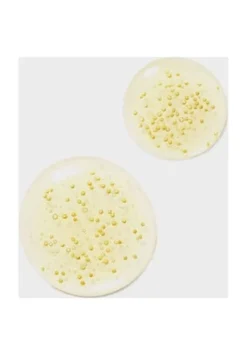
GUERLAIN ABEILLE ROYALE 8 GUERLAIN ABEILLE ROYALE -pflege Verkauf unnamed file 279

Artikelbeschreibung
Das Abeille Royale Youth Watery Oil versorgt die Haut mit leistungsstarken, exklusiv für Guerlain hergestellten Inhaltsstoffen: dem Honig der schwarzen Bienen von der französischen Insel Ouessant, Bretagne, sowie exklusivem Gelée royale. Diese revolutionäre Formel verbindet die Wirksamkeit eines Serums mit der Reichhaltigkeit eines Öls und der Frische einer Lotion. Mikrokapseln eines Öls mit aufpolsternder Wirkung verleihen Ihrem Teint ein strahlend frisches Aussehen, die Haut wirkt glatter und vitaler, sie fühlt sich unglaublich seidig und streichelzart an.
Lieferumfang
8 x 0,6 ml Double R Renew & Repair Serum, 1x Fortifying Lotion with Royal Jelly, 1x Youth Watery Oil
Serie
ABEILLE ROYALE
Zielgruppe
Damen und Herren
Anwendungsbereich
Gesicht
Pflegeprodukt-Art
Intensivpflege
Wirkung
Feuchtigkeitsspendend, Straffend, Glättend
Hauttyp
Alle Hauttypen, Reife Haut, Trockene Haut
Textur
Öl
Artikelnummer
3346470616776

Rezensionen
Es gibt noch keine Rezensionen.